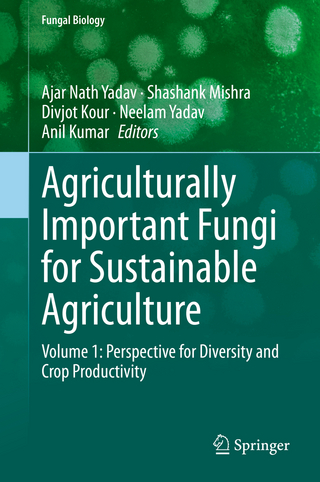
Agriculturally Important Fungi for Sustainable Agriculture

Basic Concepts and Biotechnological Applications
Buch | Softcover
2020
|
CRC Press
ISBN: 9780367571894
CHF 83,75 (inkl. MwSt)
- Versand in
15-20 Tagen